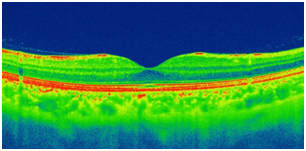

眼科(府中アイセンター)
目の病気・治療「ゆがんで見える」その症状、加齢黄斑変性かも一覧に戻る
加齢黄斑変性とは?
こんにちは、府中アイセンター通信編集担当の谷川です。
人口の高齢化や食生活の欧米化により、欧米で成人の失明原因の1位である『加齢黄斑変性』という病気が日本で増加していると聞きました。症状としては、視界がゆがんで見えたり、中心部が暗く見えたりし、50歳代以上の方の約1.3%(約70万人)には、この症状が見られ年々増加傾向にあるそうです。今回はメディカルレチナ※を専門とする当センターの眼科医である上野先生に『加齢黄斑変性』の症状、検査、治療について詳しく伺いたいと思います。
※メディカルレチナ:非手術的網膜治療(主に薬物やレーザーによる治療)
谷川:上野先生、まずは現代日本で加齢黄斑変性が増加している背景について教えてください。
上野先生:はい、名前の通り加齢黄斑変性は加齢が主な原因とされ、高齢者人口の増加に伴って増えています。その他にも生活習慣 (喫煙、紫外線、食生活など)や全身疾患 (高血圧、脂質異常)などが関係しています。
谷川:加齢黄斑変性の特徴(失明)について教えていただけますか。
上野先生:そうですね、ある日突然見えにくくなることもある病気です。
谷川:ある日、突然の視力低下ですか。とても怖いですね。前触れってありますか?
上野先生:発症早期から見え方の異常があることが多いです。初期の症状としてゆがんで見えたり、見たいところが暗く見えるなどの症状が起こりやすく、気づいたらすぐに眼科にかかることをおすすめします。
加齢黄斑変性の見え方シミュレーション
中心部が暗くぼやけ、ゆがんで見えます。
加齢黄斑変性についてもっと詳しく教えてください。
谷川:今、前触れとして、加齢黄斑変性の症状をお聞きしましたが、加齢黄斑変性について、もう少し詳しく教えていただけますか。
上野先生:加齢黄斑変性は大きく分けて萎縮型と滲出型があります。萎縮型は加齢とともに網膜の組織が委縮する病気で、視力が徐々に低下します。萎縮型には現時点で効果的な治療はありません。対して、滲出型は網膜の外側にある脈絡膜に異常な血管である新生血管ができて、それが網膜に侵入し、視機能障害を起こします。新生血管から血液成分が漏れ出し、網膜が腫れることで、ゆがみが出ます。新生血管は脆く、破れて出血することで視力が低下することもあり、大きな出血であれば急激に視力は低下します。
谷川:聞けば聞くほど怖い病気ですね。では、どのような治療法がありますか。
上野先生:治療は薬物療法(硝子体内注射)、光線力学的療法(PDT)、レーザー凝固、手術などがあります。
谷川:先生が専門とするメディカルレチナ治療について教えていただけますか。
上野先生:現在、加齢黄斑変性の治療として、主に薬物療法(硝子体内注射)が行われています 。滲出型の加齢黄斑変性では新生血管という異常血管ができるとお話ししました。その新生血管の増殖を促す原因の一つとして血管増殖因子(VEGF) が知られています。この治療は、その VEGF の働きを妨げる薬剤を眼の中に注射することで病気の活動性を抑えます。治療は日帰りで消毒・点眼麻酔の後、白目(結膜)に注射をさして眼球内に薬剤を注入します。薬は眼球内に留まり効果は数週間持続します。治療開始後は、導入期として1カ月毎に3回注射することが多いです。導入後は個々の状態に応じて治療方針が異なりますが、悪化した際に注射を追加する、もしくは計画的な注射を継続していきます。
早期発見するにはどうすればいいでしょうか?
谷川:加齢黄斑変性について、症状や治療などいろいろと教えていただきましたが、早期に発見し、治療することがとても重要だと理解できました。早期発見するためにはどうすればいいでしょうか。
上野先生:はい、50 歳を過ぎたら普段から見え方の異常を意識し、異常に気付いたらすぐに受診することが大切です。両眼に起こり得る病気ですが、片眼だけに発症すると健康な方の眼が見え方を補うことで症状に気づかないこともあります。ですから、片眼を閉じて左右交互に見え方を確認することが大事です。
自覚症状の簡単なチェック法
目線は中央の黒点におきます。目線を黒点においたままで、表の四隅はしっかりありますか? 格子状の線は真っ直ぐな直線になっていますか? どこか歪んでいたり、欠けていたりはしませんか?



参照元: https://www.moumakushikkan.com/ja/amsler
加齢黄斑変性はどのような検査をしますか?
谷川:加齢黄斑変性の検査と診断について教えてください。
上野先生:はい、視力検査など一般的な眼科検査と問診などから滲出型加齢黄斑変性が疑われた場合、さらに詳しい眼底検査、特に黄斑部を詳細に調べます。眼底の詳細な診察、光干渉断層計(OCT)や蛍光眼底造影検査で診断を進めます。OCT は、網膜やさらに奥の組織の断面を撮影し、立体的に病変を捉えることができます。蛍光眼底造影検査は造影剤を点滴しながら眼底を撮影することで、新生血管の有無や広がり、活動性を評価します。治療が始まった後も治療効果の評価、再燃など病気の活動性を評価するために定期的な診察と検査が行われます。特に OCT は体に負担をかけずに検査できるため、頻繁に行われます。
光干渉断層計(OCT:optical coherence tomography)は、網膜の断層画像を撮影する検査です。赤外線を照射し、眼底からの反射光と参照光をもとに光の干渉現象を利用して画像化したものです。

谷川:本日は加齢黄斑変性についてお話を伺いました。加齢黄斑変性以外にも糖尿病性網膜症や緑内障など視力が低下する病気は他にもありますが、府中アイセンターでは眼の病気で視力を失う方を一人でも少なくすべく、これからも地域の皆さんのクリアな視界を守る役割を担いたいと思います。
上野先生、本日はどうもありがとうございました。






